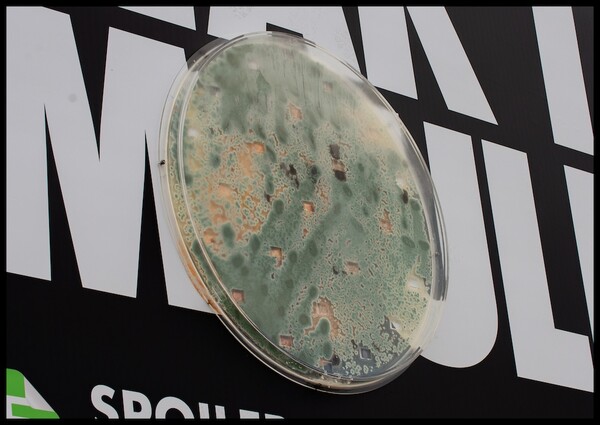
곰팡이가 핀 빵 확대 사진
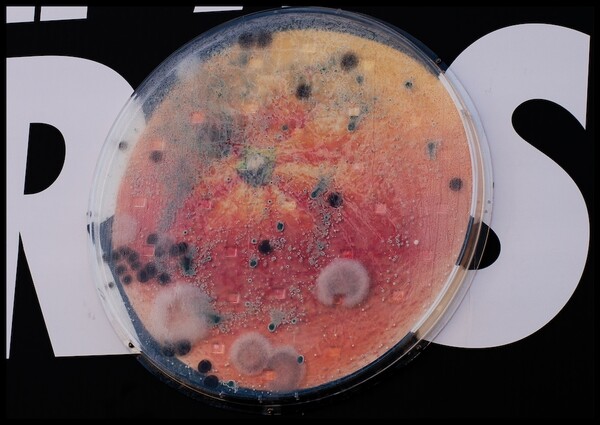
곰팡이가 핀 오렌지 확대 사진

뉴질랜드인들은 매년 32억 달러의 음식을 낭비하는 것으로 나타났다. Love Food Hate Waste NZ(LFHW)는 TBWA\뉴질랜드와 함께 2030년까지 가정용 음식물 쓰레기를 50% 줄이기 위해 곰팡이가 핀 대규모 광고판을 만들었다.
TBWA\NZ는 랜드케어 바이오메트릭스(Landcare Biometrics)와 협력하여 일반 대중에게 위험하지 않은 곰팡이가 자랄 수 있는 세 개의 거대한 페트리 접시를 특별히 만들었다. 그 곰팡이는 물론 음식에서 나온 것이었다. 블루 치즈, 페트리 접시 자체의 직경은 1m입니다. 그런 다음 옥외 광고회사 Bootleg가 독특한 살아있는 광고판을 만드는 데 참여했다.
광고판은 4월 중순에 가동되었으며 6주에 걸쳐 점차적으로 자연적으로 곰팡이가 생겼다. 이 스턴트는 대규모 음식물 쓰레기 문제에 대한 관심을 끌고 새로운 계획인 재사용 가능한 Eat Me First 스티커를 제공하기 위한 것이었다. 무료인 재사용 가능한 스티커는 OOH, LFHW 웹사이트, 지역 의회에서 QR 코드를 빠르게 스캔하여 대중에게 제공되거나 뉴질랜드 일부 울워스(Woolworth) 매장에서 무료로 받을 수 있다.
LFHW의 프로젝트 관리자인 소피 울랜드(Sophie Wolland)는 “우리의 메시지가 여러분의 얼굴에 전달되어야 했다. 음식물 쓰레기는 우리가 일상적으로 자주 생각하지 않을 만큼 심각한 문제이기 때문이다."라고 말했다.
"낭비된 음식을 적나라하게 시각적으로 표현한 것은 행인들에게 충격을 주어 행동을 하도록 유도하고, 뉴질랜드인들이 음식물 쓰레기를 줄이고, 음식물 쓰레기에서 유해한 배출을 줄여 탄소 배출량을 최소화하고, 돈을 절약하도록 동기를 부여하고 영감을 주는 것을 목표로 한다."라고 설명했다.
TBWA\NZ CCO 셰인 브랜닉(Shane Brandnick)은 "이것은 사람들이 조치를 취하도록 하기 어려운 문제 중 하나이다. 큰 관심을 끄는 묘기와 오래된 음식을 버리기 전에 먼저 먹도록 우리 모두에게 상기시키는 현명한 방법이 필요하다."라고 말했다.
"이 캠페인은 팀이 전달하기에는 매우 기술적인 내용이었지만, 우리가 그것을 먹지 않으면 낭비하게 된다는 사실을 매우 생생하게 상기시켜 주었다. 이는 가족 예산에도 좋지 않고 환경에도 정말 좋지 않다."라고 덧붙였다.

LFHW는 또한 곰팡이가 핀 음식의 거대한 기념물 몇 개로 큰 화제를 불러일으켰다. 웰링턴 해안가의 곰팡이로 뒤덮인 거대한 사과는 뉴질랜드인들에게 “나쁜 사과를 좋아하는 사람은 없다”는 점을 상기시켰고, 인근 기차역에 있는 곰팡이 핀 거대한 토스트 조각은 사람들에게 “틀을 깨뜨렸다”는 영감을 주었다.

캠페인은 브리토마트의 Te Komititanga Plaza에 있는 NZ Lamb & Beef의 16피트 높이의 양갈비로 정점에 이르렀다. 물론 곰팡이 핀 모습도 있다. 모든 캠페인 광고판 및 포스터와 마찬가지로 양갈비도 가짜 곰팡이로 뒤덮인 대중 위로 우뚝 솟아 있었다. 함께 제공되는 표지판에는 "문제의 핵심"이라고 적혀 있다.


[출처 캠페인브리프 NZ]
- 슈퍼셀 "스쿼드 버스터즈" 글로벌 론칭에 할리우드 스타들이 하나의 스쿼드로 뭉쳤다
- 홍콩 발레단 x 디자인 아미, 창립 45주년과 무용의 보편 언어를 기념하는 캠페인 공개
- 제일기획 인디아, 인도인을 하나로 묶는 정신을 기념하는 새로운 JK 타이어 광고 공개
- 맥켄 월드그룹 태국, T-POP 걸그룹 프레첼(PRETZELLE)과 'Fun-Ergy' 캠페인 론칭
- 하인즈 x 피츠로이, 음식물 쓰레기 줄이기를 위한 OOH 캠페인 출시
- 마요네즈를 만드는 헬만스는 운동화를 왜 만들었을까?
- 사치&사치, 청년에게 "핫"해지는 방법을 알려준다
- 해피니스 사이공 x 닷 바이크, 소규모 사업체를 지원하며 베트남의 정전 사태를 극복하다
- 베드헤드, 광고에서 네 번째 벽을 허물다
